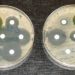
Antibiotic misconceptions persist in Medicaid-insured parents

Normotensive patients with elevated cardiovascular risk may benefit from antihypertensive pharmacotherapy
1. Regardless of cardiovascular disease history and baseline blood pressure, a 5 mmHg reduction in systolic blood pressure reduced relative risk of major cardiovascular events by 10%.
2. These findings support considering antihypertensive medications for patients with increased cardiovascular risk, even those who are normotensive at baseline.
Evidence Rating Level: 1 (Excellent)
Study Rundown: Current guidelines regarding pharmacologic reduction of systolic blood pressure for patients with increased cardiovascular risk factors lack consistency. Numerous randomized control trials have attempted to inform clinical recommendations, but insufficient information on study participants and their individual risk have limited the generalizability of these study results. This systematic review and meta-analysis uses clinical data from the Blood Pressure Lowering Treatment Trialists’ Collaboration (BPLTTC) to assess the effects of antihypertensive therapy on cohorts with different baseline blood pressures and cardiovascular disease history. The results of this study demonstrate proportional effects of pharmacologically lowered blood pressure on cardiovascular outcomes, with a 5 mmHg reduction of systolic blood pressure, on average, reducing the relative risk of major cardiovascular event by ten percent. These effects were comparable among individuals with and without previous cardiovascular disease and across all baseline systolic blood pressures. Based on these findings, pharmacologic reduction of systolic blood pressure is an effective tool for reducing risk of cardiovascular events in patients regardless of baseline blood pressure and lack of prior cardiovascular events; thus, antihypertensives should be considered for adults with cardiovascular disease risk factors.
Click to read the study in The Lancet
Relevant Reading: Association of Normal Systolic Blood Pressure Level With Cardiovascular Disease in the Absence of Risk Factors
In-Depth [systematic review and meta-analysis]: This study utilized BPLTTC trials that included information on participant baseline blood pressures, primary and secondary outcomes, and cardiovascular disease status at baseline, defined as previous reports of stroke, myocardial infarction, or ischemic heart disease. 344 716 individuals across 48 randomized control trials were included in this study. The primary outcome was defined as major cardiovascular event including fatal or non-fatal stroke, myocardial infarction, ischemic heart disease, or heart failure. Secondary outcomes included all-cause death, death attributable to cardiovascular event, and sub analysis of each primary outcome. Participants were stratified into cohorts with vs. without previous cardiovascular disease, and further sub stratified by systolic blood pressure by 10 mmHg starting from 120 mmHg. Results demonstrated that a 5 mmHg reduction in systolic blood pressure reduced the risk of major cardiovascular event by approximately 10% (13% for stroke, 13% for heart failure, 8% for ischemic heart disease, and 5% for death). Effects were comparable between participants with a previous history cardiovascular disease and those without, as well as for those with varying degrees of baseline systolic blood pressure. Because this study did not take into account individual characteristics of participants, the results are limited by population heterogeneity and nuanced differences in clinical care received. Despite this limitation, this study fills a need for comprehensive epidemiological studies to inform blood pressure management and antihypertensive treatment for individuals with cardiovascular risk factors.
Image: PD
©2021 2 Minute Medicine, Inc. All rights reserved. No works may be reproduced without expressed written consent from 2 Minute Medicine, Inc. Inquire about licensing here. No article should be construed as medical advice and is not intended as such by the authors or by 2 Minute Medicine, Inc.